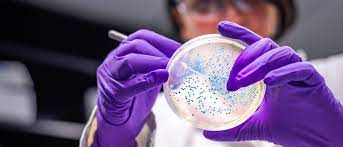
MDFinsights's tweet image. The global microbiology testing market is predicted to grow USD 8.48 billion by 2027, growing at a CAGR of 11.8% during the forecast period 2022 to 2027.
For more insights @ bit.ly/3Ry6SDz
#microbiologytesting #microbiologytestingmarket #marketdataforecast

#marketdataforecast kết quả tìm kiếm
Data on Wheels: Why High-Capacity Storage is Essential for Modern Cars According to a report by #MarketDataForecast, the connected car opportunity in India will grow as big as USD 32.5.. To Read Complete News👉digitalterminal.in/opinion/data-o… #WesternDigital #StorageSolution

The size of the global coagulation/hemostasis analyzer market is predicted to grow USD 4.84 billion by 2027, growing at a CAGR of 10.2% during the forecast period 2022 to 2027. For more insights @ bit.ly/3AXMxBG #hemostasisanalyzermarket #marketdataforecast

The Grain Analysis Market was worth USD 2.35 billion in 2021 and is expected to grow at a CAGR of 6.12 % to reach USD 3.17 billion from 2021 to 2027. To Read More @ bit.ly/grain-analysis… #grainanalysis #grainanalysismarket #marketdataforecast

The global renewable chemicals market was valued at USD 56 billion in 2021, registering a CAGR of 17.47% to reach USD 84.3 billion by 2026. To Read More @ bit.ly/3e4bNNA #renewablechemicals #renewablechemicalsmarket #marketdataforecast

The size of the global methadone market is expected to grow at a decent CAGR during the forecast period 2022 to 2027. For more insights @ bit.ly/3wFOmjT #methadone #methadonemarket #marketdataforecast

The Package Film Market was worth US$ 141.5 billion in 2021. It is projected to reach a valuation of US$ 197.6 billion by 2027, registering a CAGR of 3.9% from 2022-2027. To Read More @ bit.ly/3ekFAl7 #packagefilm #packagefilmmarket #marketdataforecast

The global smart pill technology market is projected to grow USD 7973.88 million by 2027, to grow at a CAGR of 17.5% during the forecast period 2022 to 2027. For more insights @ bit.ly/3TrgDV6 #smartpilltechnology #smartpilltechnologymarket #marketdataforecast

The size of the global respiratory inhaler market is estimated to grow at a decent CAGR of 4.4% during the forecast period 2022 to 2027. For more insights @ bit.ly/3QbC49P #respiratoryinhalermarket #respiratoryinhaler #marketdataforecast

The global preclinical CRO market is predicted to be worth USD 5.68 billion by 2027, to grow at a CAGR of 8.3% during the forecast period 2022 to 2027. For more insights @ bit.ly/3ADQppX #preclinicalcro #preclinicalcromarket #marketdataforecast

The size of the global rubella vaccine market is projected to grow at a significant CAGR during the forecast period 2022 to 2027. For more insights @ bit.ly/3R9lM2F #rubellavaccinemarket #rubellavaccine #marketdataforecast

The global microbiology testing market is predicted to grow USD 8.48 billion by 2027, growing at a CAGR of 11.8% during the forecast period 2022 to 2027. For more insights @ bit.ly/3Ry6SDz #microbiologytesting #microbiologytestingmarket #marketdataforecast

The global thin film drugs market is estimated to be worth USD 34.55 billion by 2027, growing at a CAGR of 10.50% during the forecast period 2022 to 2027. For more insights @ bit.ly/3q9FIqj #thinfilmdrugs #thinfilmdrugsmarket #marketdataforecast

The Paper Coating Materials Market is expected at USD 6.70 billion in 2021 and is anticipated to extent an over of USD 8.53 billion by the end of the assessment period. To Read More @ bit.ly/3AD3Tk2 #papercoatingmaterials #papercoatingmaterialsmarket #marketdataforecast

The global intravenous ibuprofen market is expected to be worth USD 20.48 billion by 2027, growing at a CAGR of 20% during the forecast period 2022 to 2027. For more insights @ bit.ly/3R6fgK3 #intravenousibuprofen #intravenousibuprofenmarket #marketdataforecast

The size of the global hospital lighting market is expected to reach USD 10.89 billion by 2027, to grow at a CAGR of 6.3% during the forecast period 2022 to 2027. For more insights @ bit.ly/2XXTIUA #hospitallighting #hospitallightingmarket #marketdataforecast

The size of the global medical device technology market is expected to be worth USD 747.90 million by 2027, growing at a CAGR of 5.6% during the forecast period 2022 to 2027. For more insights @ bit.ly/3Ksfybw #medicaldevicetechnology #marketdataforecast #researchreport

The global neonatal phototherapy equipment market is predicted to grow USD 646.42 million by 2027, growing at a CAGR of 4.5% during the forecast period 2022 to 2027. For more insights @ bit.ly/3RbLcwD #neonatalphototherapyequipment #marketdataforecast #researchreport

The global intra-abdominal pressure measurement devices market is anticipated to grow USD 152.71 million by 2027, to grow at a CAGR of 16.5% during the forecast period 2022 to 2027. For more insights @ bit.ly/2WMS8qY #ipmd #ipmdmarket #marketdataforecast #researchreport

is.gd/wXHNng #Gin distillato 2022: il mercato globale è in crescita e si è ora portato a 14 Miliardi $ #Featured #MarketDataForecast #MercatoAlcolici #ProduzioneGin #ScottishDevelopmentInternational

The Corn Fiber Market was worth US$ 765 million in 2021 and is anticipated to reach the valuation of US$ 2300 million by 2027 and is predicted to register a CAGR of 13.89% during 2022-2027. To Read More @ bit.ly/3REx9zB #cornfiber #cornfibermarket #marketdataforecast
is.gd/wXHNng #Gin distillato 2022: il mercato globale è in crescita e si è ora portato a 14 Miliardi $ #Featured #MarketDataForecast #MercatoAlcolici #ProduzioneGin #ScottishDevelopmentInternational

The Grain Analysis Market was worth USD 2.35 billion in 2021 and is expected to grow at a CAGR of 6.12 % to reach USD 3.17 billion from 2021 to 2027. To Read More @ bit.ly/grain-analysis… #grainanalysis #grainanalysismarket #marketdataforecast

The Corn Fiber Market was worth US$ 765 million in 2021 and is anticipated to reach the valuation of US$ 2300 million by 2027 and is predicted to register a CAGR of 13.89% during 2022-2027. To Read More @ bit.ly/3REx9zB #cornfiber #cornfibermarket #marketdataforecast
The Package Film Market was worth US$ 141.5 billion in 2021. It is projected to reach a valuation of US$ 197.6 billion by 2027, registering a CAGR of 3.9% from 2022-2027. To Read More @ bit.ly/3ekFAl7 #packagefilm #packagefilmmarket #marketdataforecast

The size of the global hospital lighting market is expected to reach USD 10.89 billion by 2027, to grow at a CAGR of 6.3% during the forecast period 2022 to 2027. For more insights @ bit.ly/2XXTIUA #hospitallighting #hospitallightingmarket #marketdataforecast

The global thin film drugs market is estimated to be worth USD 34.55 billion by 2027, growing at a CAGR of 10.50% during the forecast period 2022 to 2027. For more insights @ bit.ly/3q9FIqj #thinfilmdrugs #thinfilmdrugsmarket #marketdataforecast

The global microbiology testing market is predicted to grow USD 8.48 billion by 2027, growing at a CAGR of 11.8% during the forecast period 2022 to 2027. For more insights @ bit.ly/3Ry6SDz #microbiologytesting #microbiologytestingmarket #marketdataforecast

The global intra-abdominal pressure measurement devices market is anticipated to grow USD 152.71 million by 2027, to grow at a CAGR of 16.5% during the forecast period 2022 to 2027. For more insights @ bit.ly/2WMS8qY #ipmd #ipmdmarket #marketdataforecast #researchreport

The size of the global rubella vaccine market is projected to grow at a significant CAGR during the forecast period 2022 to 2027. For more insights @ bit.ly/3R9lM2F #rubellavaccinemarket #rubellavaccine #marketdataforecast

The global preclinical CRO market is predicted to be worth USD 5.68 billion by 2027, to grow at a CAGR of 8.3% during the forecast period 2022 to 2027. For more insights @ bit.ly/3ADQppX #preclinicalcro #preclinicalcromarket #marketdataforecast

The size of the global respiratory inhaler market is estimated to grow at a decent CAGR of 4.4% during the forecast period 2022 to 2027. For more insights @ bit.ly/3QbC49P #respiratoryinhalermarket #respiratoryinhaler #marketdataforecast

The global neonatal phototherapy equipment market is predicted to grow USD 646.42 million by 2027, growing at a CAGR of 4.5% during the forecast period 2022 to 2027. For more insights @ bit.ly/3RbLcwD #neonatalphototherapyequipment #marketdataforecast #researchreport

The global intravenous ibuprofen market is expected to be worth USD 20.48 billion by 2027, growing at a CAGR of 20% during the forecast period 2022 to 2027. For more insights @ bit.ly/3R6fgK3 #intravenousibuprofen #intravenousibuprofenmarket #marketdataforecast

The size of the global methadone market is expected to grow at a decent CAGR during the forecast period 2022 to 2027. For more insights @ bit.ly/3wFOmjT #methadone #methadonemarket #marketdataforecast

The size of the global coagulation/hemostasis analyzer market is predicted to grow USD 4.84 billion by 2027, growing at a CAGR of 10.2% during the forecast period 2022 to 2027. For more insights @ bit.ly/3AXMxBG #hemostasisanalyzermarket #marketdataforecast

The global smart pill technology market is projected to grow USD 7973.88 million by 2027, to grow at a CAGR of 17.5% during the forecast period 2022 to 2027. For more insights @ bit.ly/3TrgDV6 #smartpilltechnology #smartpilltechnologymarket #marketdataforecast

The size of the global medical device technology market is expected to be worth USD 747.90 million by 2027, growing at a CAGR of 5.6% during the forecast period 2022 to 2027. For more insights @ bit.ly/3Ksfybw #medicaldevicetechnology #marketdataforecast #researchreport

The global renewable chemicals market was valued at USD 56 billion in 2021, registering a CAGR of 17.47% to reach USD 84.3 billion by 2026. To Read More @ bit.ly/3e4bNNA #renewablechemicals #renewablechemicalsmarket #marketdataforecast

The Paper Coating Materials Market is expected at USD 6.70 billion in 2021 and is anticipated to extent an over of USD 8.53 billion by the end of the assessment period. To Read More @ bit.ly/3AD3Tk2 #papercoatingmaterials #papercoatingmaterialsmarket #marketdataforecast

The global healthcare gamification market size is projected to value USD 7733 million by 2027 from USD 1302 million in 2022, growing at a CAGR of 42.8% from 2022 to 2027. #healthcare #healthcaregamificationmarket #marketdataforecast bit.ly/3PO2Hl7
Data on Wheels: Why High-Capacity Storage is Essential for Modern Cars According to a report by #MarketDataForecast, the connected car opportunity in India will grow as big as USD 32.5.. To Read Complete News👉digitalterminal.in/opinion/data-o… #WesternDigital #StorageSolution

is.gd/wXHNng #Gin distillato 2022: il mercato globale è in crescita e si è ora portato a 14 Miliardi $ #Featured #MarketDataForecast #MercatoAlcolici #ProduzioneGin #ScottishDevelopmentInternational

The size of the global coagulation/hemostasis analyzer market is predicted to grow USD 4.84 billion by 2027, growing at a CAGR of 10.2% during the forecast period 2022 to 2027. For more insights @ bit.ly/3AXMxBG #hemostasisanalyzermarket #marketdataforecast

The size of the global patient flow management solution market is forecasted to reach USD 2270.26 million by 2027, growing at a CAGR of 21.32% from 2022 to 2027. For more insights @ bit.ly/3AptEpN #patientflowmanagementsolutionsmarket #marketdataforecast

The Grain Analysis Market was worth USD 2.35 billion in 2021 and is expected to grow at a CAGR of 6.12 % to reach USD 3.17 billion from 2021 to 2027. To Read More @ bit.ly/grain-analysis… #grainanalysis #grainanalysismarket #marketdataforecast

The size of the global methadone market is expected to grow at a decent CAGR during the forecast period 2022 to 2027. For more insights @ bit.ly/3wFOmjT #methadone #methadonemarket #marketdataforecast

The global renewable chemicals market was valued at USD 56 billion in 2021, registering a CAGR of 17.47% to reach USD 84.3 billion by 2026. To Read More @ bit.ly/3e4bNNA #renewablechemicals #renewablechemicalsmarket #marketdataforecast

The Package Film Market was worth US$ 141.5 billion in 2021. It is projected to reach a valuation of US$ 197.6 billion by 2027, registering a CAGR of 3.9% from 2022-2027. To Read More @ bit.ly/3ekFAl7 #packagefilm #packagefilmmarket #marketdataforecast

The global microbiology testing market is predicted to grow USD 8.48 billion by 2027, growing at a CAGR of 11.8% during the forecast period 2022 to 2027. For more insights @ bit.ly/3Ry6SDz #microbiologytesting #microbiologytestingmarket #marketdataforecast
The global thin film drugs market is estimated to be worth USD 34.55 billion by 2027, growing at a CAGR of 10.50% during the forecast period 2022 to 2027. For more insights @ bit.ly/3q9FIqj #thinfilmdrugs #thinfilmdrugsmarket #marketdataforecast

The global preclinical CRO market is predicted to be worth USD 5.68 billion by 2027, to grow at a CAGR of 8.3% during the forecast period 2022 to 2027. For more insights @ bit.ly/3ADQppX #preclinicalcro #preclinicalcromarket #marketdataforecast

The size of the global respiratory inhaler market is estimated to grow at a decent CAGR of 4.4% during the forecast period 2022 to 2027. For more insights @ bit.ly/3QbC49P #respiratoryinhalermarket #respiratoryinhaler #marketdataforecast

The size of the global rubella vaccine market is projected to grow at a significant CAGR during the forecast period 2022 to 2027. For more insights @ bit.ly/3R9lM2F #rubellavaccinemarket #rubellavaccine #marketdataforecast

The global smart pill technology market is projected to grow USD 7973.88 million by 2027, to grow at a CAGR of 17.5% during the forecast period 2022 to 2027. For more insights @ bit.ly/3TrgDV6 #smartpilltechnology #smartpilltechnologymarket #marketdataforecast

The size of the global hospital lighting market is expected to reach USD 10.89 billion by 2027, to grow at a CAGR of 6.3% during the forecast period 2022 to 2027. For more insights @ bit.ly/2XXTIUA #hospitallighting #hospitallightingmarket #marketdataforecast

The global intravenous ibuprofen market is expected to be worth USD 20.48 billion by 2027, growing at a CAGR of 20% during the forecast period 2022 to 2027. For more insights @ bit.ly/3R6fgK3 #intravenousibuprofen #intravenousibuprofenmarket #marketdataforecast

The Paper Coating Materials Market is expected at USD 6.70 billion in 2021 and is anticipated to extent an over of USD 8.53 billion by the end of the assessment period. To Read More @ bit.ly/3AD3Tk2 #papercoatingmaterials #papercoatingmaterialsmarket #marketdataforecast

The global digital dental impression devices market is poised to grow at a healthy CAGR during the forecast period 2022 to 2027. For more insights @ bit.ly/3CvAIUo #digitaldentalimpressiondevices #digitaldentalimpressiondevicesmarket #marketdataforecast

The global bioseparation systems market is poised to grow USD 7.2 billion by 2027, to grow at a CAGR of 9.1% during the forecast period 2022 to 2027. For more insights @ bit.ly/3TcLkNX #bioseparationsystems #bioseparationsystemsmarket #marketdataforecast

The global intra-abdominal pressure measurement devices market is anticipated to grow USD 152.71 million by 2027, to grow at a CAGR of 16.5% during the forecast period 2022 to 2027. For more insights @ bit.ly/2WMS8qY #ipmd #ipmdmarket #marketdataforecast #researchreport

Something went wrong.
Something went wrong.
United States Trends
- 1. #StrangerThings5 220K posts
- 2. Thanksgiving 660K posts
- 3. BYERS 48K posts
- 4. robin 85.3K posts
- 5. Reed Sheppard 5,265 posts
- 6. Afghan 274K posts
- 7. Podz 4,050 posts
- 8. holly 60.9K posts
- 9. Dustin 89.4K posts
- 10. National Guard 648K posts
- 11. Gonzaga 8,403 posts
- 12. Vecna 53.4K posts
- 13. hopper 15K posts
- 14. Jonathan 73.3K posts
- 15. Erica 16.1K posts
- 16. Amen Thompson 1,684 posts
- 17. #AEWDynamite 21.7K posts
- 18. noah schnapp 8,667 posts
- 19. derek 17.9K posts
- 20. Tini 9,063 posts



